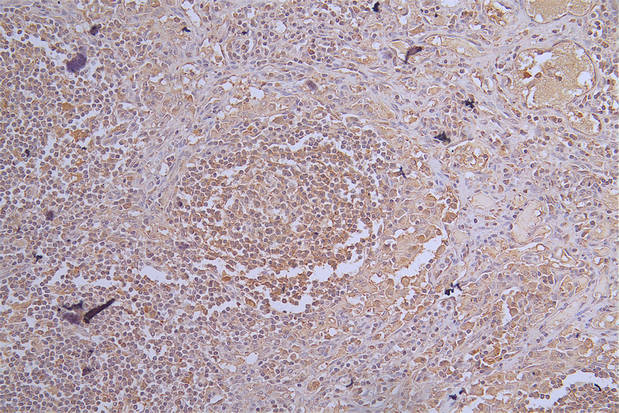

CR1 Antibody
-
中文名稱:CR1兔多克隆抗體
-
貨號:CSB-PA822164ESR1HU
-
規(guī)格:¥440
-
圖片:
-
Western Blot
Positive WB detected in: THP-1 whole cell lysate, TF-1 whole cell lysate, Mouse Spleen tissue lysate
All lanes: CR1 antibody at 1:500
Secondary
Goat polyclonal to rabbit IgG at 1/50000 dilution
Predicted band size: 224/270 kDa
Observed band size: 270 kDa -
Immunohistochemistry of paraffin-embedded human lymph node tissue using CSB-PA822164ESR1HU at dilution of 1:100
-
Immunofluorescence staining of MCF-7 cells with CSB-PA822164ESR1HU at 1:25, counter-stained with DAPI. The cells were fixed in 4% formaldehyde, permeabilized using 0.2% Triton X-100 and blocked in 10% normal Goat Serum. The cells were then incubated with the antibody overnight at 4°C. The secondary antibody was Alexa Fluor 488-congugated AffiniPure Goat Anti-Rabbit IgG(H+L).
-
-
其他:
產(chǎn)品詳情
-
產(chǎn)品描述:
The recombinant human CR1 protein (420-550AA) is used to immunize the ribbit to generate the anti-CR1 antibody. This CR1 polyclonal antibody occurs as an unconjugated IgG. It is purified by antigen affinity and reaches a relatively high purity. And it only shows reactivity with human CR1 protein, also called CD35, which is responsible for the Knops blood group on erythrocytes. Human CR1 is involved in the clearance of complement-opsonized molecules and may facilitate pathogens' entry into host cells. This CR1 antibody is suitable for ELISA, WB, and IHC applications.
-
產(chǎn)品名稱:Rabbit anti-Homo sapiens (Human) CR1 Polyclonal antibody
-
Uniprot No.:
-
基因名:
-
別名:C3 binding protein antibody; C3b/C4b receptor antibody; C3BR antibody; C4BR antibody; CD 35 antibody; CD35 antibody; CD35 antigen antibody; complement component (3b/4b) receptor 1 (Knops blood group) antibody; complement component (3b/4b) receptor 1 including Knops blood group system antibody; Complement component receptor 1 antibody; Complement receptor 1 antibody; Complement receptor type 1 antibody; CR 1 antibody; CR1 antibody; CR1_HUMAN antibody; KN antibody; Knops blood group antigen antibody
-
宿主:Rabbit
-
反應種屬:Human, Mouse
-
免疫原:Recombinant Human Complement receptor type 1 protein (420-550AA)
-
免疫原種屬:Homo sapiens (Human)
-
標記方式:Non-conjugated
-
克隆類型:Polyclonal
-
抗體亞型:IgG
-
純化方式:Antigen Affinity Purified
-
濃度:It differs from different batches. Please contact us to confirm it.
-
保存緩沖液:PBS with 0.02% sodium azide, 50% glycerol, pH7.3.
-
產(chǎn)品提供形式:Liquid
-
應用范圍:ELISA, WB, IHC, IF
-
推薦稀釋比:
Application Recommended Dilution WB 1:1000-1:5000 IHC 1:20-1:200 IF 1:20-1:200 -
Protocols:
-
儲存條件:Upon receipt, store at -20°C or -80°C. Avoid repeated freeze.
-
貨期:Basically, we can dispatch the products out in 1-3 working days after receiving your orders. Delivery time maybe differs from different purchasing way or location, please kindly consult your local distributors for specific delivery time.
-
用途:For Research Use Only. Not for use in diagnostic or therapeutic procedures.
相關(guān)產(chǎn)品
靶點詳情
-
功能:Membrane immune adherence receptor that plays a critical role in the capture and clearance of complement-opsonized pathogens by erythrocytes and monocytes/macrophages. Mediates the binding by these cells of particles and immune complexes that have activated complement to eliminate them from the circulation. Acts also in the inhibition of spontaneous complement activation by impairing the formation and function of the alternative and classical pathway C3/C5 convertases, and by serving as a cofactor for the cleavage by factor I of C3b to iC3b, C3c and C3d,g, and of C4b to C4c and C4d. Plays also a role in immune regulation by contributing, upon ligand binding, to the generation of regulatory T cells from activated helper T cells.; (Microbial infection) Acts as a receptor for Epstein-Barr virus.
-
基因功能參考文獻:
- this study correlated phenotype data (CR1 density per erythrocyte (CR1/E), blood soluble CR1 (sCR1)) with genetic data (density/length polymorphisms) in AD patients and healthy controls.. PMID: 30044434
- CR1 rs1704660G, rs17047661G and rs6691117G variants were significantly associated with Chagas disease. PMID: 29323238
- Meta-analysis validated the association of late onset Alzheimer disease with CR1 (rs6656401) variants. PMID: 29504051
- rs6656401 CR1 is not associated with late-onset Alzheimer's disease. PMID: 28477215
- CR1 plays a vital role in Alzheimer's disease pathology and disease progression. PMID: 26742530
- the effect of CR1 rs3818361 polymorphism on Alzheimer's disease (AD) risk in Chinese cohorts is consistent with the increased risk observed in European AD cohorts. PMID: 26189835
- Genetic variation within the CR1 gene is associated with inflammation and the risk of incident coronary artery disease. PMID: 28033544
- The distribution of the CR1 alleles, genotypes and haplotypes differed significantly among population in Brazil, Vietnam, India, Republic of Congo and Ghana. PMID: 28520715
- CD16 and CD35 are important for neutrophil internalization of M. tuberculosis, whereas HIV-1 infection adversely affects opsonophagocytosis. PMID: 27258232
- This study demonstrates an up-regulation of complement regulatory proteins, CD35 and CD55 in HIV associated pre-eclamptic compared to normotensive pregnancy. PMID: 27521598
- Although B lymphocytes of active systemic lupus erythematosus (SLE) patients express lower level of CR1, the inhibitory capacity of this complement receptor is still maintained and its ligand-induced clustering results in significant inhibition of the main B cell functions, similar to that found in the case of healthy individuals. PMID: 27981054
- CyaA binding did not trigger downstream signaling of CR3 in human monocytes and CyaA-catalyzed elevation of cAMP effectively blocked CR3 signaling initiated by a natural ligand. PMID: 26650353
- the Putative Role of CR1 in Alzheimer's Disease PMID: 26914463
- Knops blood group antigen a/b genotype was associated with increased susceptibility to severe malaria and the b/b genotype was associated with reduced risk of severe malaria. PMID: 25916414
- The C4d/CR1 ratio is a simple and quickly determinable biomarker that enables the differentiation between infection and flare-up in febrile SLE patients at initial evaluation. PMID: 26273660
- This meta-analysis further supports previous findings that CR1 rs6656401 polymorphism contributes to Alzheimer's Disease susceptibility. PMID: 24878768
- Complement receptor type 1 (CR1/CD35) expressed on activated human CD4+ T cells contributes to generation of regulatory T cells PMID: 25742728
- These results provide a framework for understanding how loss of CR1 expression on podocytes may contribute to complement-mediated damage in the kidney. PMID: 26260209
- findings provide evidence that the A carrier (AG/GG) and the A allele of the ECR1 A3650G polymorphism may be correlated to the pathogenesis of NRDS and, hence, might be involved in the susceptibility to NRDS. PMID: 25494101
- THE COMBINATION OF EXPRESSION OF MARKERS CR1 AND CR2 (CD35/CD21) IN DIAGNOSTIC OF B-CELL LYMPHOPROLIFERATIVE DISEASES PMID: 26189291
- CR1 gene rs2274567 G/A, rs4844600 G/A, and rs2296160 C/T polymorphisms may not be involved in susceptibility to malaria in Chinese population. PMID: 25683978
- In addition to being a risk factor for Alzheimer's disease development, a CR1 SNP appears to be associated with higher rates of medium-term disease progression PMID: 24998857
- Data indicate that complement activation promote complement component 3 C3b deposition on native and acetylated LDL and binding to the complement receptor 1 (CR1). PMID: 25349208
- A meta-analysis demonstrated significant associations of both the CR1 rs6656401 and CR1 rs3818361 polymorphisms with late-onset Alzheimer's disease susceptibility. PMID: 24996192
- CR1 SNPs correlates with specific aspects of cognitive impairment in Alzheimer's disease patients. PMID: 24530172
- This study identified nominally significant or suggestive associations between the LOAD-risky CR1 variants and worse Logical Memory immediate recall scores in blacks. PMID: 23643458
- Increased CR1 expression was associated with histology classification. PMID: 23464487
- CR1 rs7525160 G > C polymorphism was associated with an increased risk of developing non-small cell lung cancer in Chinese population PMID: 24621201
- Polymorphism of the complement receptor 1 gene correlates with the hematologic response to eculizumab in patients with paroxysmal nocturnal hemoglobinuria. PMID: 24038027
- this is the first study to elucidate the relationship of the L-CR1 transcript with the disease activity of RA patients. PMID: 24433281
- Using mutagenesis and structural biology to map the binding site for the Plasmodium falciparum merozoite protein PfRh4 on the human immune adherence receptor. PMID: 24214979
- Maternal coding variants in complement receptor 1 is associated with spontaneous idiopathic preterm birth. PMID: 23591632
- two Alzheimer's disease-associated CR1 variants, rs6656401 and rs3818361, are associated with major recurrent depression in females in a population-based cohort using individuals from the Generation Scotland: Scottish Family Health Study PMID: 22244847
- It did not explain (part of) the association of genome wide association top single-nucleotide polymorphisms rs3818361/rs6656401, nor of the CR1copy number variation, with Alzheimer disease in our cohort PMID: 23582656
- ATP release following CR1 ligation increases the mobility of the lipid fraction of RBC membranes, which in turn facilitates CR1 clustering, and thereby enhances the binding avidity of complement-opsonized particles to the RBC CR1. PMID: 24022490
- Data show that increased CD35, CD46, CD55 and CD59 on neutrophils and monocytes present potent markers of bacterial infection and viral infection. PMID: 23376460
- The CD35 antigen bounds gp350/220 and became latently infected when the fusion receptor HLA II was coexpressed. PMID: 23416052
- Genome-wide association studies found 3 new susceptibility loci for Alzheimer disease(AD): complement receptor 1,clusterin,and the phosphatidylinositol-binding clathrin assembly protein. These SNPS are not associated with AD in a Polish population. PMID: 23650005
- Our findings suggest complex mechanisms underlying the interaction of CR1, APOE, and brain amyloid pathways in Alzheimer disease PMID: 23022416
- Complement receptor type 1 (CR1, CD35) is a potent inhibitor of B-cell functions in rheumatoid arthritis patients. PMID: 22962438
- We identified rare small events overlapping CR1 and BIN1 in Alzheimer's disease and normal controls with opposite copy number variation dosage. PMID: 23202439
- Malaria inhibits surface expression of complement receptor 1 in monocytes/macrophages, causing decreased immune complex internalization. PMID: 23440418
- There are fewer mono- or dinucleated, but dramatically more numbers of tri- or polynucleated megakaryocytes in the bone marrow of transgenic Crry mice. PMID: 23390291
- Common CR1 variants significantly protect against severe malaria in an endemic area. PMID: 23152904
- In conclusion, despite there are some limitations, this meta-analysis indicates that the A allele of the CR1 SNP rs6656401 is significantly associated with LOAD susceptibility in Chinese Han populations. PMID: 22960360
- The clustering phenomenon of CR1 in erythrocytes is identified in electron microscopy. PMID: 22374251
- our results support that the CR1-S isoform explains the GWAS signals and open a novel prospect for the investigation of CR1-related disease mechanisms. PMID: 22819390
- Simultaneous quantitative analysis of CD64 and CD35 expression on neutrophils might be useful to distinguish between bacterial and viral infections in rheumatoid arthritis patients. PMID: 22237765
- CR1 (CD35) and CR3 (CD11b/CD18) act in concert for phagocytosis of opsonized Francisella tularensis by human neutrophils. PMID: 22888138
- CLU and CR1 were associated with more rapid cognitive decline. PICALM was associated with an earlier age at midpoint of cognitive decline. PMID: 22952074
顯示更多
收起更多
-
亞細胞定位:Membrane; Single-pass type I membrane protein.
-
蛋白家族:Receptors of complement activation (RCA) family
-
組織特異性:Present on erythrocytes, a subset of T cells, mature B cells, follicular dendritic cells, monocytes and granulocytes.
-
數(shù)據(jù)庫鏈接:
Most popular with customers
-
-
YWHAB Recombinant Monoclonal Antibody
Applications: ELISA, WB, IHC, IF, FC
Species Reactivity: Human, Mouse, Rat
-
-
-
-
-
-